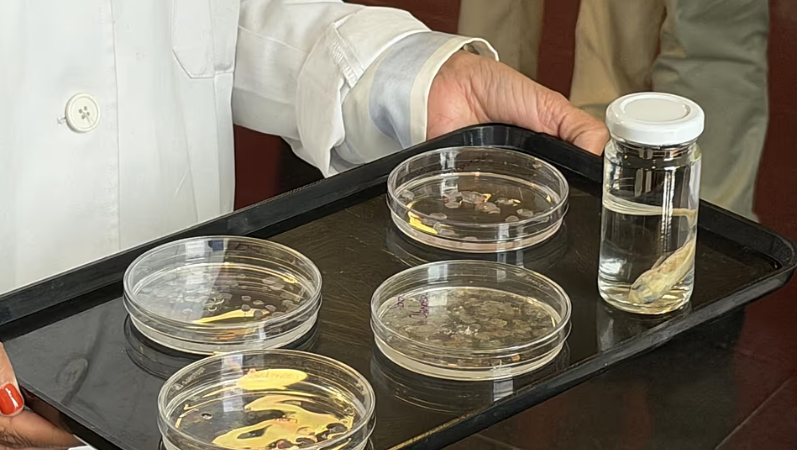

Shkencëtarët kanë gjetur një burim të ri për implantet korneale: luspat e peshkut që tregjet i hedhin çdo ditë.
Studiuesit në Departamentin e Histologjisë të Universitetit të Granadës në Spanjë kanë kaluar vite duke studiuar këtë material të lënë pas dore dhe gjetjet e tyre mund t’u ofrojnë shpresë mijëra pacientëve që vuajnë në listat e pritjes për transplantim.
Duke analizuar luspat e krapit dhe peshqve të tjerë që hahen zakonisht, ekipi ka zhvilluar një implant të qendrueshëm dhe transparent, të aftë për të riparuar kornean e dëmtuar.
Kornea, shtresa e tejdukshme në pjesën e përparme të syrit është e vështirë për t’u trajtuar kur është e dëmtuar rëndë. Shërohet më ngadalë dhe nuk ka furnizim të drejtpërdrejtë me gjak, duk i lënë mjekët me pak mundësi përtej një transplanti të plotë. Por indi i donatorit është i pakët dhe kërkesa tejkalon shumë furnizimin.
“Është e nevojshme të zhvillohen metoda të reja efektive të rigjenerimit që nuk varen nga dhurimi i organeve”, thotë Miguel Alaminos, profesor i Histologjisë në Universitetin e Granadës dhe një nga autorët kryesorë të studimit.
Studimi, i botuar në revistën ‘Materials & Design’, përshkruan se si një analizë e plotë e luspave mundësoi zhvillimin e një biomateriali me veti të përshtatshme për riparimin e kornesë. Testet e kryera si në kushte laboratorike ashtu edhe në kafshë eksperimentale kanë dhënë rezultate të mira funksionale.
Përtej interesit klinik, studiuesit nxjerrin në pah një avantazh praktik: origjina e materialit e bën atë të lirë dhe lehtësisht të disponueshëm. Luspat e peshkut janë një nënprodukt i industrisë së peshkimit që, në shumë raste, thjesht hidhen. Shndërrimi i tij në një lëndë të parë për implantet mjekësore hap një përdorim potencial që mund të ketë dhe pasoja ekonomike.
Rezultatet aktuale janë paraprake, por mjaftueshëm të forta për të justifikuar vazhdimin. Faza laboratorike dhe testet në kafshë kanë kaluar filtrat e parë, por përpara se ky lloj implanti të arrijë në sallën e operacionit, është e nevojshme të përfundojnë provat klinike tek njerëzit, një proces që zakonisht zgjat me vite dhe kërkon rregullore të rrepta.
Copyright © Gazeta “Si”
Të gjitha të drejtat e këtij materiali janë pronë ekskluzive dhe e patjetërsueshme e Gazetës “Si”, sipas Ligjit Nr.35/2016 “Për të drejtat e autorit dhe të drejtat e tjera të lidhura me to”. Ndalohet kategorikisht kopjimi, publikimi, shpërndarja, tjetërsimi etj, pa autorizimin e Gazetës “Si”, në të kundërt çdo shkelës do mbajë përgjegjësi sipas nenit 179 të Ligjit 35/2016.
.png)

Lini një Përgjigje